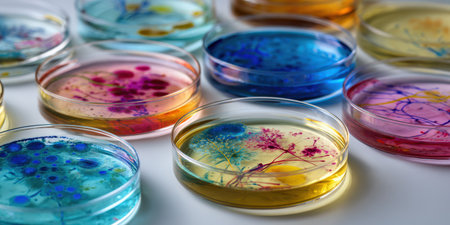
Petri dishes holding vibrant liquid cultures with colorful bacteria and scientific samples, representing laboratory research, microbiology, and pharmaceutical developmentの素材

素材 - Petri dishes holding vibrant liquid cultures with colorful bacteria and scientific samples, representing laboratory research, microbiology, and pharmaceutical development
作品情報
Petri dishes holding vibrant liquid cultures with colorful bacteria and scientific samples, representing laboratory research, microbiology, and pharmaceutical development
- ID:254837305
- 作品種別:
- 作者名:Olga Khelmitskaya
キーワード
- abstract
- analysis
- bacteria
- biology
- biotechnology
- chemistry
- colorful
- concept
- culture
- development
- discovery
- disease
- education
- environment
- experiment
- fluid
- glass
- growth
- health
- healthcare
- innovation
- investigation
- laboratory
- labware
- liquid
- medical
- microbiology
- microscopic
- petri dish
- pharmaceutical
- pharmaceuticals
- research
- sample
- science
- scientific
- solution
- study
- technology
- testing
- vivid
類似作品
A hand scrubs a...
many empty whit...
Many colorful c...
A congested sin...
Potter in studi...
Stack of colour...
A chef standing...
Stack of white ...
Close-up of sta...
A dish rack wit...
drying dishes w...
Dirty sink with...
lots of dirty w...
Pottery plate a...
Lots of dirty d...
Rustic wooden s...
Stack of colorf...
Colorful plates...
colorful plates...
close-up of dis...
White ceramic p...
Still life serv...
A vibrant arran...
Colorful Plates...
A woman is wash...
Hands scrub cle...
Plates layer on...
A kitchen count...
Stack of white ...
Ceramic plates ...
open dishwasher...
A vibrant colle...
Colorful small ...
Woman holding s...
Help with feedi...
drying rack fil...
A beautifully o...
Rows of empty p...
black cups are ...
Kitchen, hands ...
Close up of a p...
white plates an...
A stunning over...
Stack of colorf...
A stack of colo...
In a cozy kitch...
A collection of...
lots of dirty w...